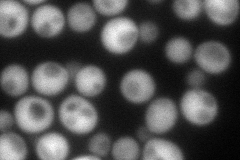
YOR283W
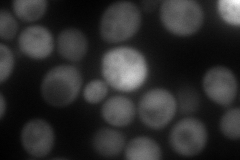
YOR283W
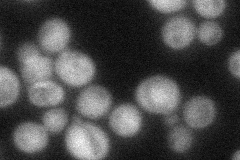
YOR283W
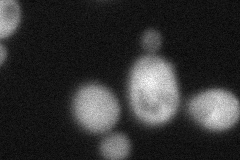
YOR283W
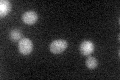
YOR283W
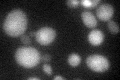
YOR283W

View description
Phosphatase with some similarity to GPM1/YKL152C, a phosphoglycerate mutase; YOR283W is not an essential gene
Localization:
Intensity:
Fold change:
Significance:
-
C’ GFP library in SD

cytosol92.39 -
N' NOP1pr-GFP in SD
cytosol,punctate138.729 -
N' TEF2pr-mCherry in SD
cytosol200.24 -
N' NATIVEpr-GFP in SD
cytosol52.9013 -
N' TEF2pr-VC and Cyto-VN in SD
cytosol64.8334 -
C’ GFP library in SD+DTT

cytosol87.080.94No -
C’ GFP library in SD+H2O2

cytosol69.620.75No -
C’ GFP library in Starvation Media
cytosol46.650.5No -
C’ GFP library on the background of Pup2-DaMP
punctate -
C’ GFP library on the background of CCT mutant

cytosol70.85670.766899No
